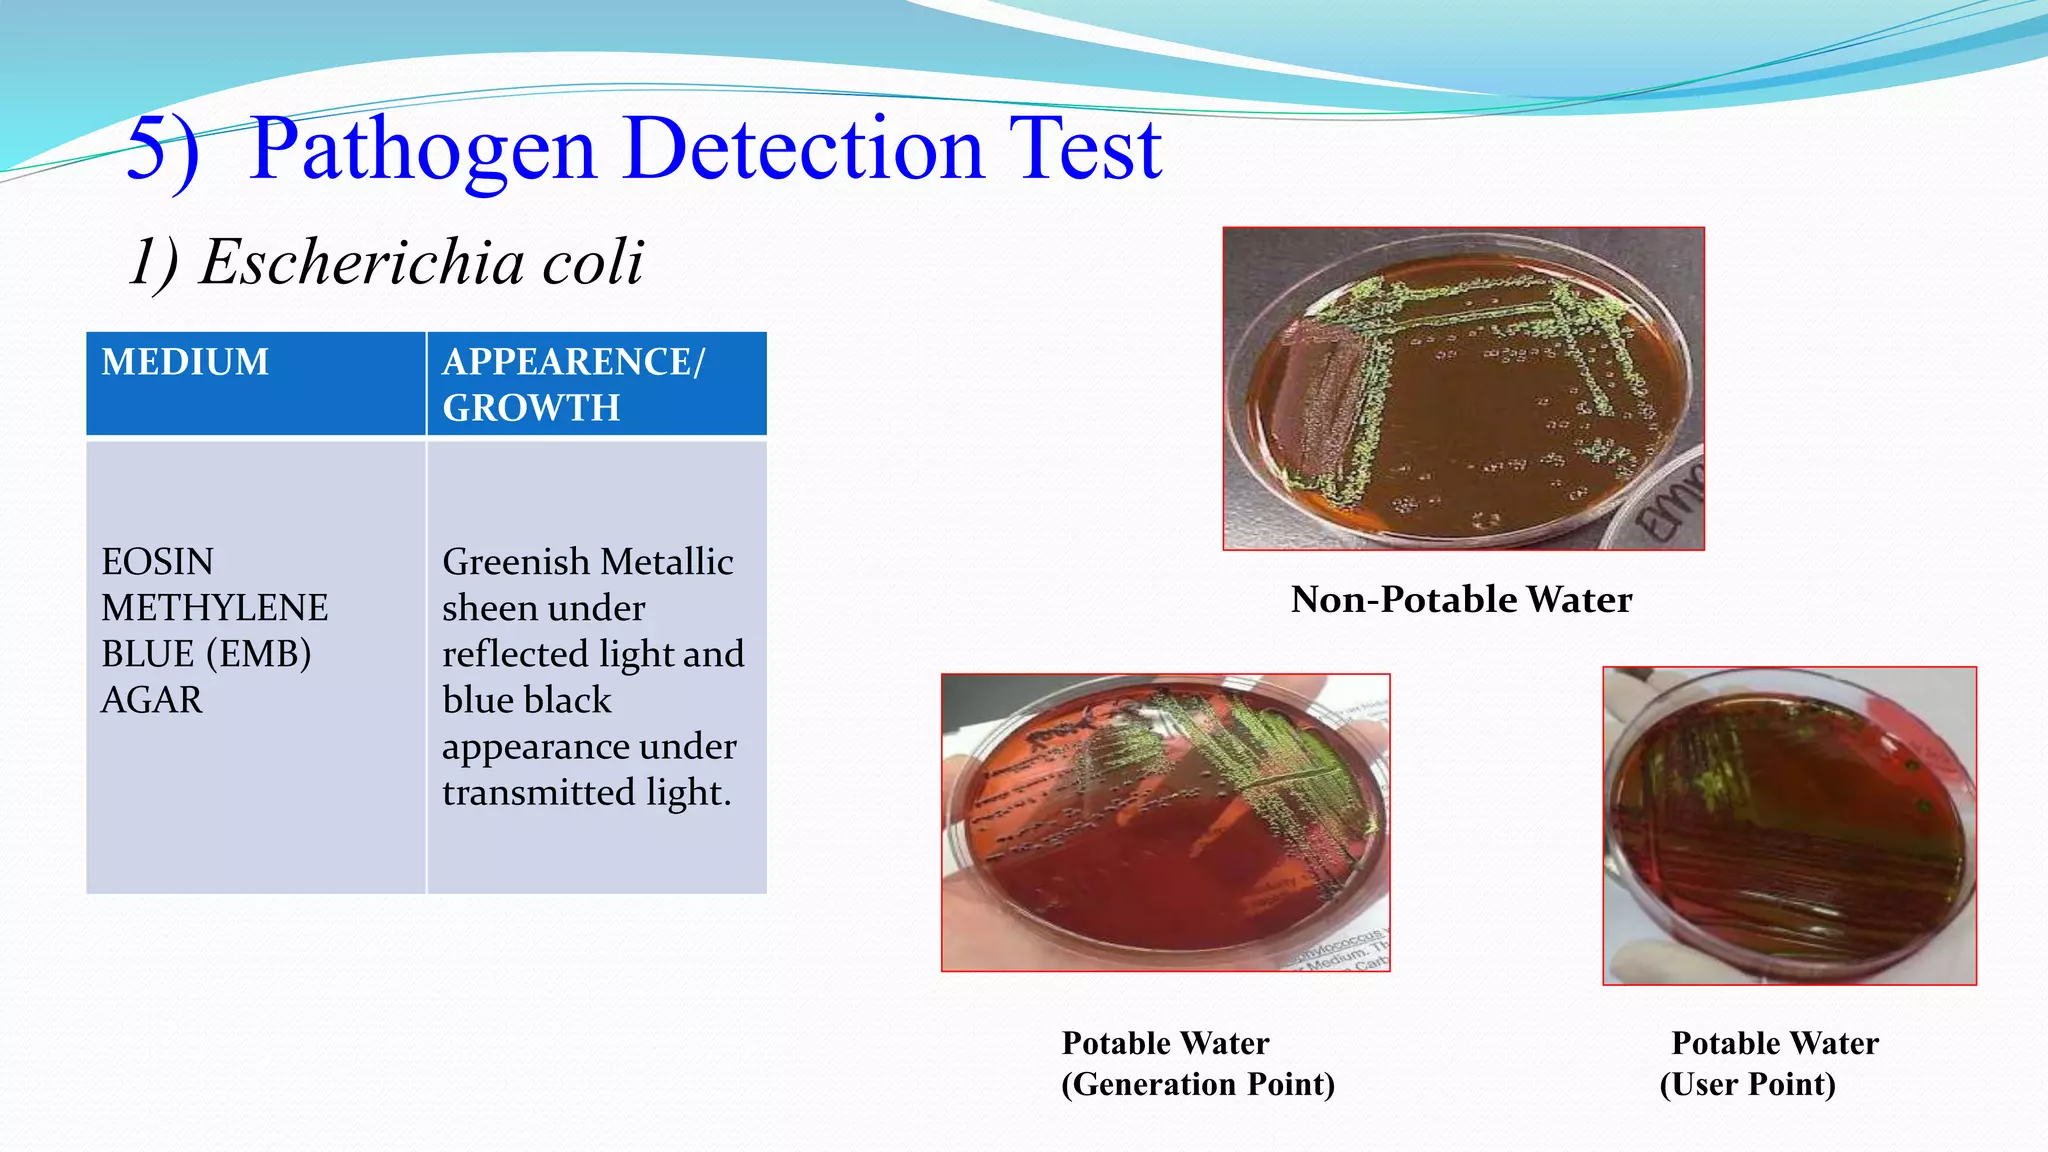
5) Pathogen Detection Test
MEDIUM APPEARENCE/
GROWTH
EOSIN
METHYLENE
BLUE (EMB)
AGAR
Greenish Metallic
sheen under
reflected light and
blue black
appearance under
transmitted light.
1) Escherichia coli
Non-Potable Water
Potable Water Potable Water
(Generation Point) (User Point)
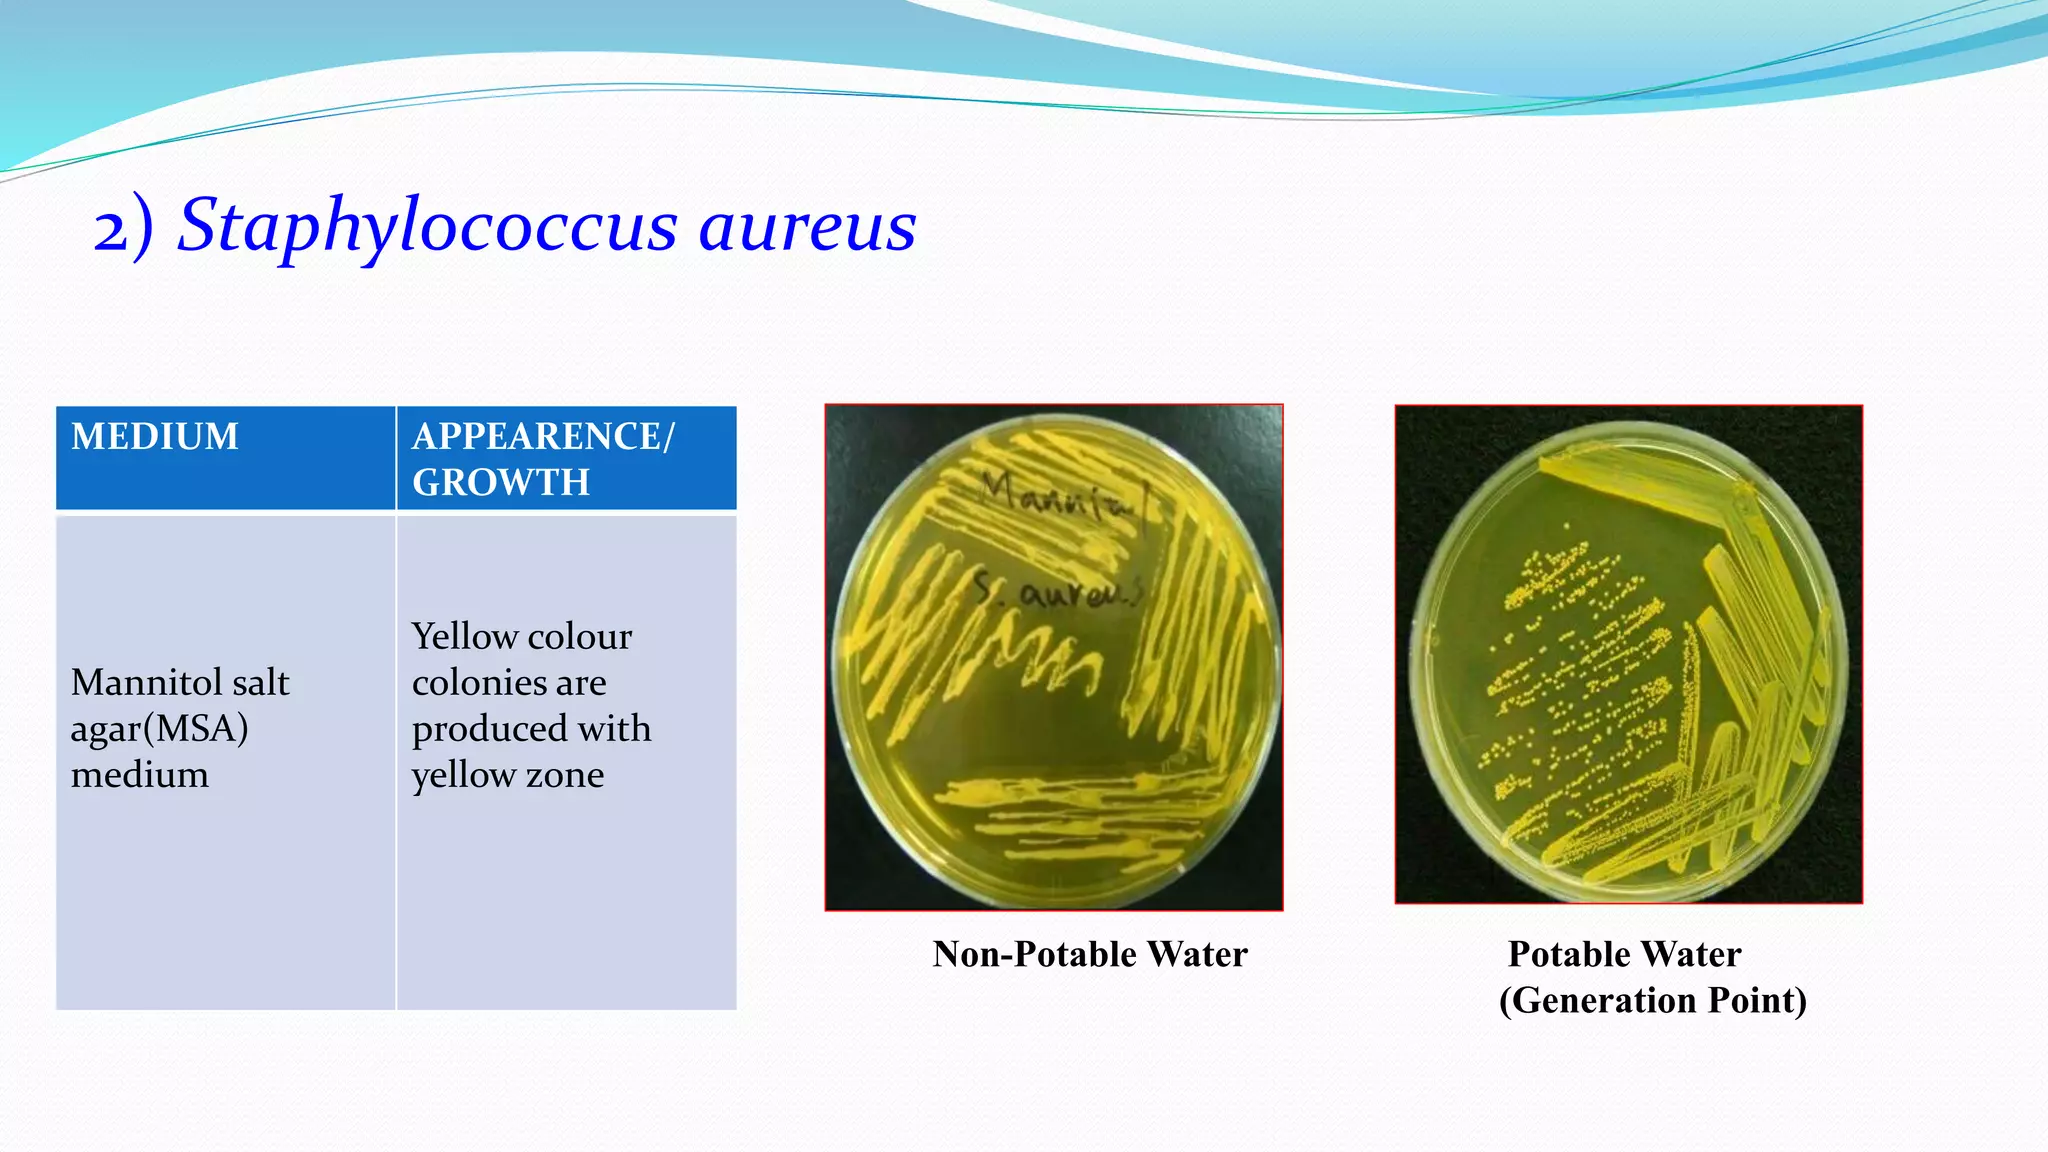
MEDIUM APPEARENCE/
GROWTH
Mannitol salt
agar(MSA)
medium
Yellow colour
colonies are
produced with
yellow zone
2) Staphylococcus aureus
Non-Potable Water Potable Water
(Generation Point)
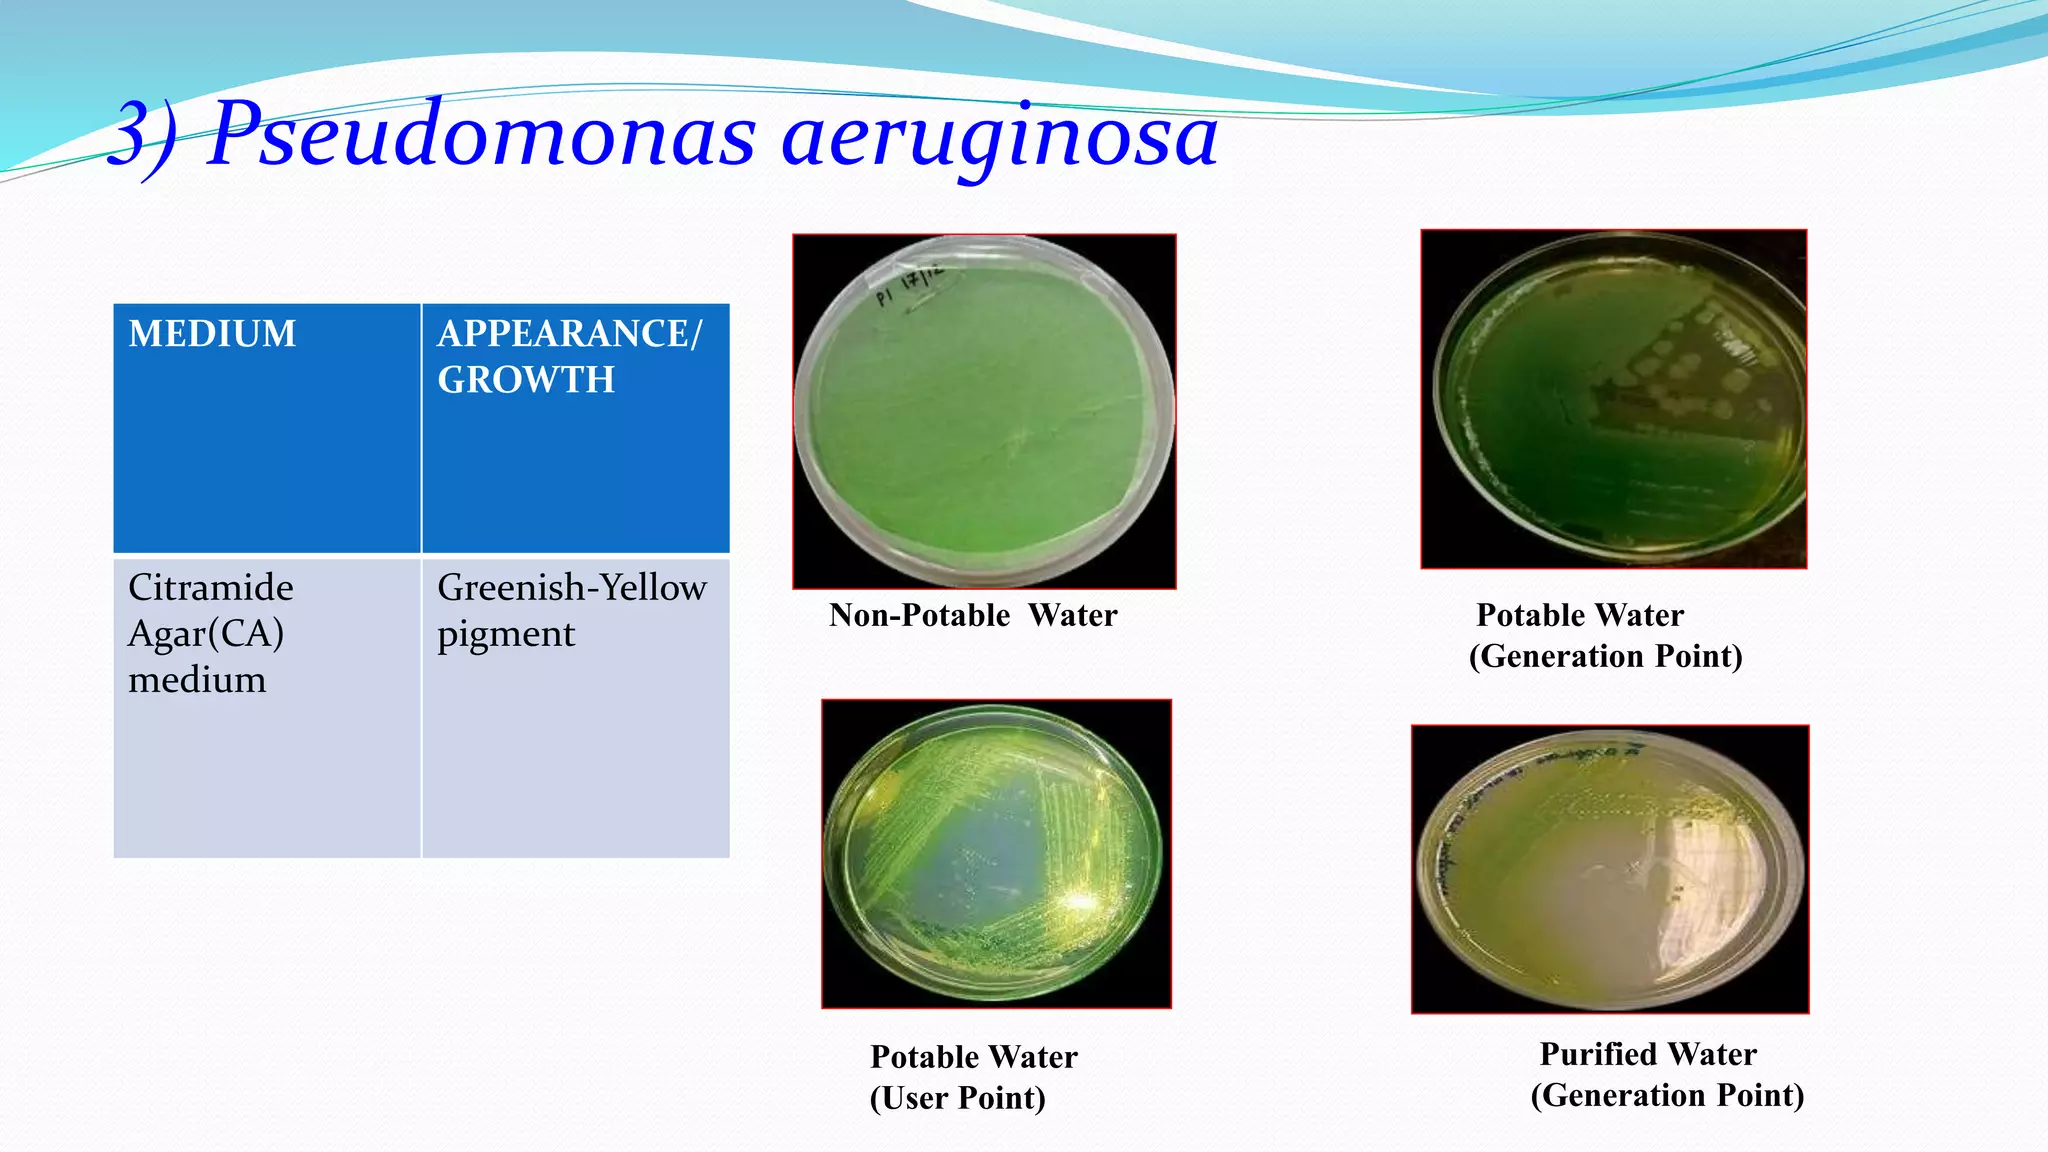
MEDIUM APPEARANCE/
GROWTH
Citramide
Agar(CA)
medium
Greenish-Yellow
pigment
3) Pseudomonas aeruginosa
Non-Potable Water Potable Water
(Generation Point)
Potable Water
(User Point)
Purified Water
(Generation Point)

The document presents an analysis of microbial quality in various grades of water used in veterinary vaccine manufacturing, emphasizing the importance of microbiological control. It describes methods for testing water samples including microbial limit tests and bacterial endotoxin tests, highlighting potential pathogens and results from different water sources. Overall, the findings confirm that potable water, purified water, and water for injection meet microbiological safety acceptance limits essential for vaccine production.